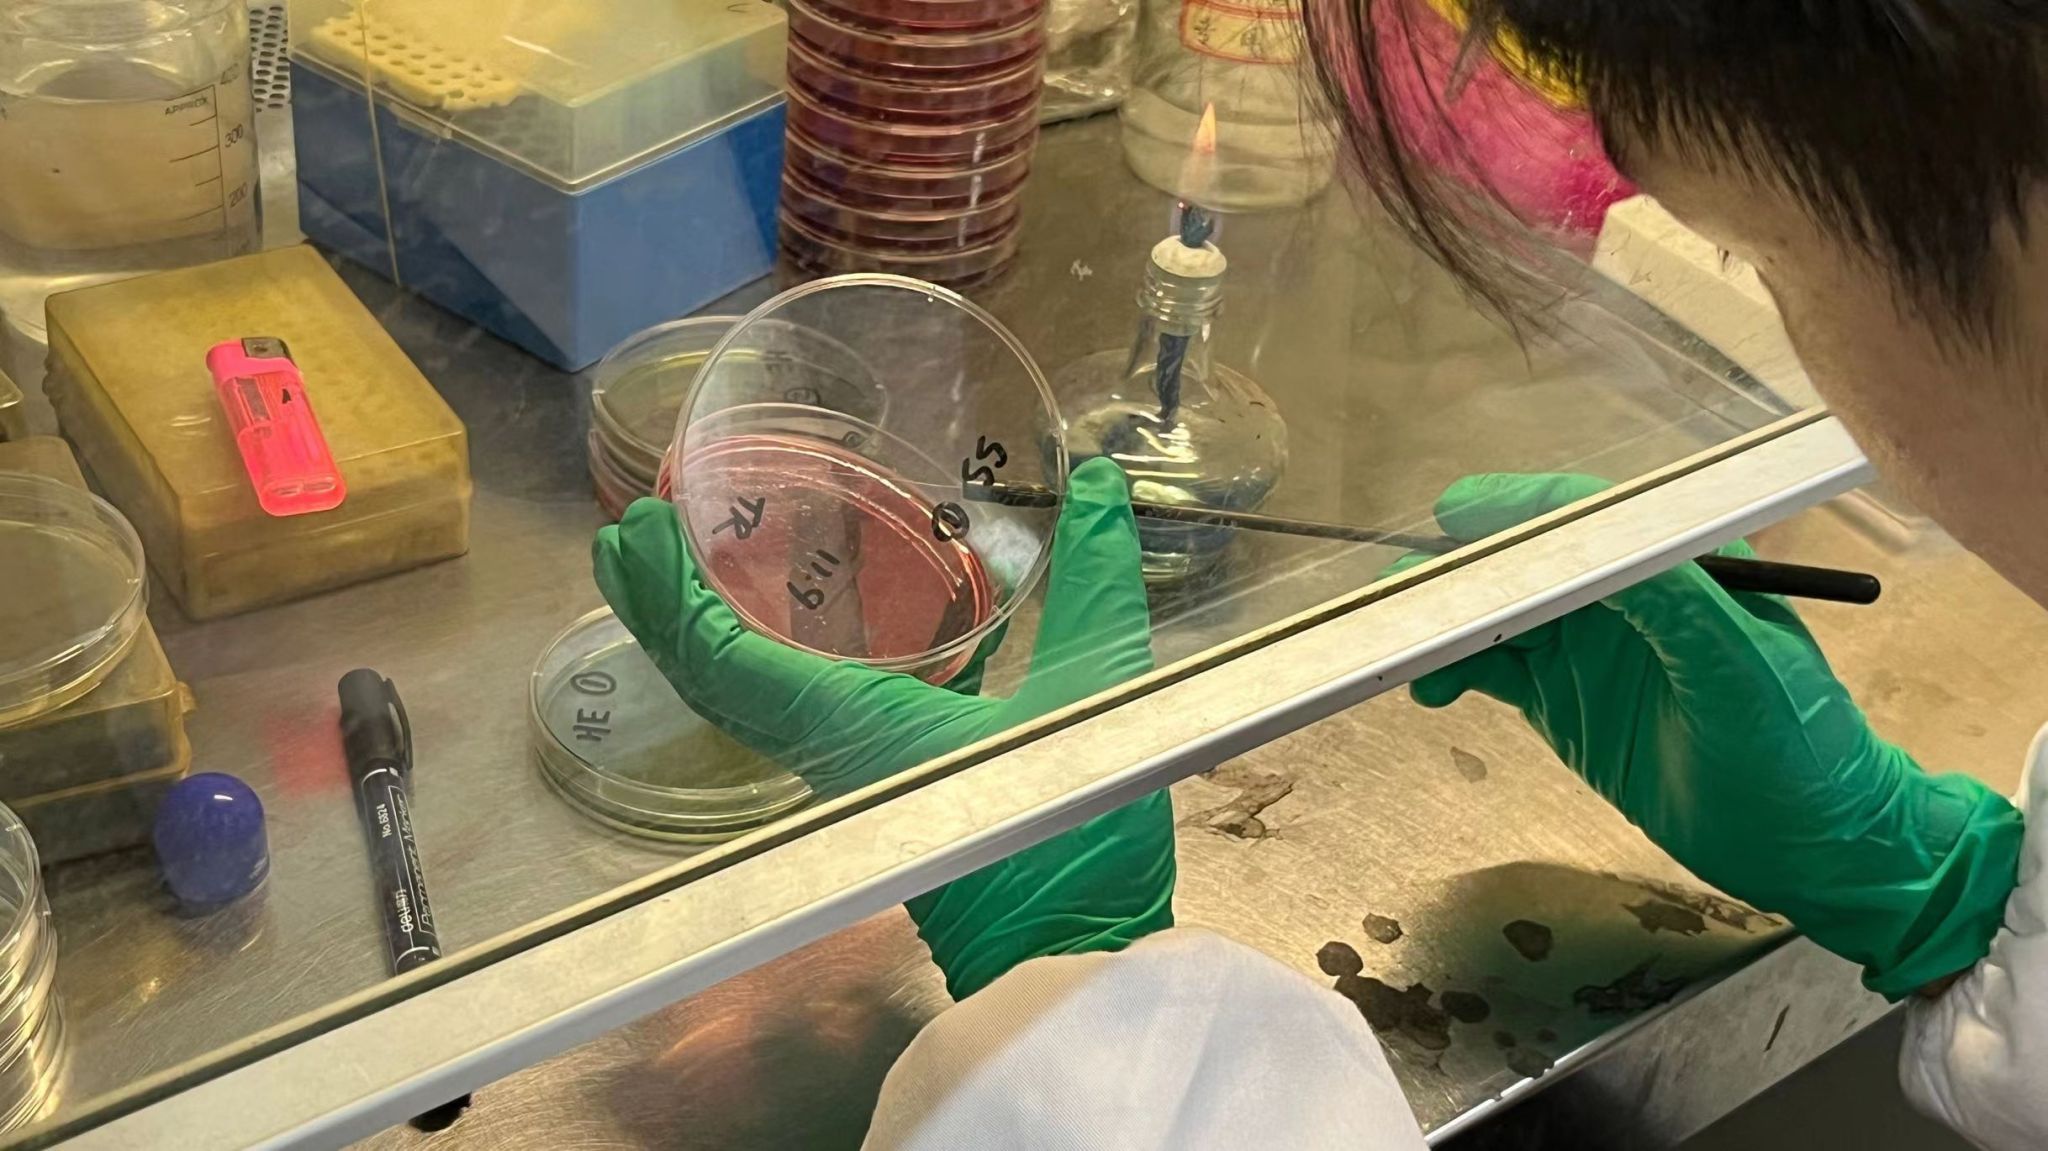

7月5日至年8月29日,冰球突破mg正规官网的一项科研兴趣“四川省圈养林麝养殖地区市售牛肉沙门菌的分离鉴定与耐药性分析”实验在暑假于六教实验楼进行最后的实验冲刺,利用假期时间,科研兴趣小组的5名成员,从成都周边超市、菜市场、生鲜超市采集的30个样本与都江堰周边的超市、菜市场采集的10个样本进行了50余次实验操作,最终在8月20号从市售牛肉中分离提取出沙门菌。
沙门虽小,危害巨大
在中国,由沙门菌引起的病例数占细菌性食物中毒的首位,每年有超过300万人次的食物中毒与之有关。沙门菌主要通过两种途径传播:一是肉类、蛋类、奶类及相关制品生产、加工、储存及销售过程中污染沙门菌,从而引起中毒;二是通过接触沙门菌污染高发的环境而被感染但其最主要通过受污染的食源性动物制品传播。本科研兴趣就针对市售牛肉这一产品进行沙门菌的检测,对了解调查地区市售牛肉沙门菌的耐药情况及丰富食源性沙门菌的耐药性资料具有一定的参考价值。
克服困难,检测沙门
本次实验最先在成都周边的超市以及菜市场进行市售牛肉样本的采集,俗话说“民以食为天”,自2009年颁布食品安全法以来,食品安全在国家层面受到前所未有的高度重视。生牛在养殖场饲养后送往屠宰场到最后送到各个销售点,都是要经过重重检疫严格把关,所以目前的中国市场要从市售牛肉检测出沙门菌的几率可以说是很小的。科研兴趣小组在进行了30个市售牛肉样品的实验后依然没有分离出沙门菌。项目负责人陈晔在采访中打趣到:“每次看实验结果都是怀着复杂的心情,没有检测出沙门就意味着实验没能成功,心情会有些低落,但这也意味着成都关于市售牛肉的食品安全是十分可靠的,又十分的欣慰。”
每批针对市售牛肉里面细菌的分离鉴定:从预增菌到增菌再到分离培养最后PCR基因扩增后进行沙门菌的测定,大概为五天一个循环。起初成员们怀着奋斗到底的信念,积极前往各个超市、菜市场采集牛肉样本,但是在前30个牛肉样本都没能分离出沙门菌的时候,成员们都出现了疲态,花费了大量的时间精力却依然没有取得实质性的实验成果。本次科研兴趣的指导老师罗燕教授在了解情况后鼓励成员们:“从市售牛肉中提取沙门确实是比较困难的,很少,但是如果真的提取到那说明这株沙门的抗逆性很强,可以针对其性质进行很多有意义的实验,有很好的前景,现在才30多个样本,样本数量还不够,加油,相信你们可以。”
图为科研兴趣小组成员唐睿在对实验样品进行平板划线
功夫不负有心人,在持续了一个暑假的实验,累计采集了40个样本,终于在8月20日第12个循环实验中分离提取出一株沙门菌。目前小组成员已经将此株沙门菌送去有康生物科技有限公司进行基因测序以便检测这一株沙门菌的更多相关信息,从而了解市售牛肉沙门菌污染的现状,为食品安全献出自己的一份力。

